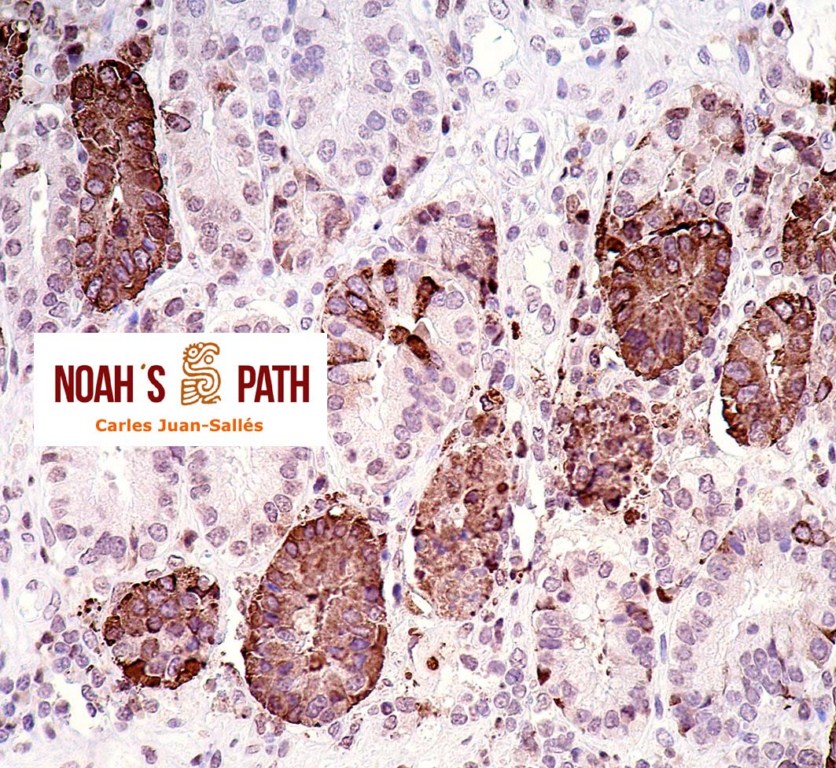

Noah's Path participó con 4 estudios en la International Conference on Diseases of Zoo and Wild Animals 2015
Noah's Path participó en la International Conference on Diseases of Zoo and Wild Animals 2015 en Barcelona (13-16 Mayo) con la presentación de una comunicación oral (estudio retrospectivo de criptosporidiosis en aves) y tres pósteres (espiruridiasis proventricular en 14 psitácidas, espirorquidiasis sistémica en dos galápagos europeos (Emys orbicularis), y colitis por coronavirus en elands (Taurotragus oryx)). Esperamos que estas actividades contribuyan al desarrollo de la medicina de estas especies y sean de utilidad también para nuestra clientela, a la que agradecemos su confianza continuada en nuestros servicios de diagnóstico y por su imprescindible contribución de casuística a estos y otros estudios en los que Noah’s Path participa.
 |
 |
|
 |
||